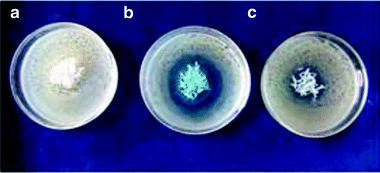
Fig. 3.9

Abstract
Bioactive copper nanomaterials are an emerging class of nano-antimicrobials providing complimentary effects and characteristics, as compared to other nano-sized metals, such as silver or zinc oxide nanoparticles. In this chapter, copper nano-antimicrobials are reviewed and classified firstly as a function of the preparation methods, and secondly as a function of the target microorganism used for testing their antimicrobial activity. The antimicrobial activity of copper-based nanostructures depends on the microbial species and on the experimental set-up. As a consequence, in this chapter details are provided on methods, as well as on experimental details such as contact time, microorganism strain, concentration of the interacting species, etc. Finally, real-life applications of copper-based nanoantimicrobials are briefly discussed.
Keywords: Copper Nanoparticles, Minimum Bactericidal Concentration, Glass Powder, Hollow Nanospheres, Copper Oxide Nanoparticles
Introduction
There is a great concern about the resistance of microorganisms towards multiple antibiotics or disinfecting agents, therefore great efforts are being devoted to the development of novel and effective agents against pathogenic microorganisms [1]. Several real-life applications could be involved including food processing and packaging, health care and biomedical devices, surgery and implants, disinfection of hospitals, textiles, household furnishing and paints, airports, and production facilities; these needs might have implications even in more extreme scenarios, such as germ warfare, space exploration, and in the prevention of pandemic diseases like SARS (Severe Acute Respiratory Syndrome), influenza viruses, etc.
In this regard, the development of non-conventional antibacterial and antifungal agents is becoming a key research field. Recently, inorganic bactericides have attracted special interest due to their activity, chemical stability, and heat resistance [2, 3]. Furthermore, the development of nanoscience and nanotechnology presents novel opportunities for exploring the bactericidal effect of innovative nanomaterials containing metals with a marked bioactivity such as silver, copper, and zinc [3–7], to cite just a few.
In most studies on metal-based nano-antimicrobials, the biological effectiveness of the material is demonstrated to be significantly higher or longer than the (well-known) bioactivity of the bulk metal itself. This has been suggested to be due to several aspects, including the nano-metal size-dependent properties, as well as the high surface-to-volume ratio of ultrafine particles, and, finally, non-conventional features related to the presence of surface stabilizers. In fact, capping agents have been frequently demonstrated to tune the nanoparticle ionic release and, consequently, its anti-biofilm properties.
The need for hygienic living conditions prompts new challenges for the development of affordable and efficacious antimicrobial materials that should be environmentally friendly and absolutely non-toxic towards human beings.
Finely dispersed bioactive nanomaterials are expected to exert an improved disinfecting effect due to their size, providing higher environmental mobility and allowing them to interact closely with bacterial membranes. On the other hand, the same properties may give rise to severe risks for human health, thus greatly limiting the development of nanoparticle real-life applications.
The growing international concern in nanoparticle toxicology towards humans is presently supporting the development of “smart” nano-antimicrobials. Such nontoxic nanomaterials can still reduce the risks of transmitting diseases by preventing microorganism survival and proliferation in several application contexts, but are also expected to ensure environmental compatibility and absence of human toxicity, since they are impregnated or covalently linked or co-polymerized or somehow confined in a dispersing/supporting matrix. The latter component acts as an immobilizing component in a nanocomposite formulation or a hybrid nanomaterial, and it might also bring additional properties to the final product coating.
The usefulness of copper as an antibacterial agent has been known for a long time. Different forms of copper compounds were used by ancient civilizations for several afflictions and to maintain hygiene [8]. The ancient Egyptians sterilized drinking water and wounds using metals such as silver and copper. The Romans catalogued numerous medicinal uses of copper for various diseases. The Aztecs treated sore throats with copper, while in Persia and India, copper was applied to treat boils, eye infections, and venereal ulcers [9].
Soluble copper compounds have been shown to provide excellent antimicrobial activity against a number of microorganisms including bacteria, fungi, algae, and viruses, while these species are relatively safe for humans [10]. Copper appears to exert its killing effect by generating reactive hydroxyl radicals that can cause irreparable damage such as the oxidation of proteins, cleavage of DNA and RNA molecules, and membrane damage due to lipid peroxidation [11, 12].
Bioactivity of copper, both as free ion and complex species, is well-known and has been documented for many years; nevertheless, only few papers and patents have been issued so far about the antibacterial properties of copper-containing nano-sized materials [13–15].
This chapter focuses on the synthesis and bioactivity of antimicrobial copper nanomaterials and on their applications to real life.
The number of publications dealing with possible approaches to the synthesis of copper nanomaterials is very large, and the authors have recently published a specific review dealing with copper nano-phases [16]. In the present chapter, we have focused our attention only on those papers where the antimicrobial properties of copper nanomaterials were explicitly assessed.
These studies are here reviewed and classified firstly as a function of the synthesis approach and secondly as a function of the target microorganism used for testing the antimicrobial activity.
Synthesis of Cu Nano-Antimicrobials
Several approaches to the preparation of copper nanomaterials are nowadays available. Plenty of details are available in a recent review specifically dealing with the synthesis and characterization of copper nanomaterials [16]. In the present chapter, the different studies dealing with antimicrobial copper nanomaterials have been classified on the basis of the preparation method. Three different classes of syntheses are outlined in the following: chemical, electrochemical, and physical/mechanical approaches.
Chemical Approaches
The redox syntheses of metal nanomaterials, including copper, are certainly the most frequently used, and they are usually indicated as wet-chemical processes. Key aspects of the overall synthetic method include the choice of the reaction medium and the stabilizer agent, the experimental conditions (pressure, temperature, microwave assistance, etc.), and the use of additional dispersing/supporting materials. Some of these issues will be explicitly assessed in the following sub-paragraphs.
Unsupported Copper Nanoparticles
Among the simplest processes, the direct reduction of a salt (such as copper nitrate) into copper nanoparticles (CuNPs) has to be mentioned. As an example, Ruparelia et al. have reported on the synthesis of CuNPs involving the well-known wet-chemical reaction between sodium borohydride and copper nitrate, used as precursor. The resulting nanoparticles were dried in a reducing environment and stored in air-tight containers until biological testing. The presence of nanoparticles in suspension would ensure a continuous release of ions into the nutrient media [17]. Many redox processes can be used similarly. Among these, we outline the possible use of vitamin C [18], citrate [19], glucose [20] or similar nutrients/food additives to reductively produce CuNP colloids. At present, these nanomaterials have not been tested specifically as nano-antimicrobials, although such an application could have unprecedented advantages from the use of non-toxic reductants in the colloidal formulation.
Recently, low-polydispersion copper nanoparticles (NPs) (Fig. 3.1) and nanorods (CuNRs) (Fig. 3.2) were synthesized by thermal decomposition of copper (II) acetylacetonate [Cu(acac)2] precursors in the presence of surfactants [21]. CuNPs were synthesized in phenyl ether using Cu(acac)2 as a salt precursor, oleyamine as a surfactant, and 1,2- tetradecanediol as a reducing agent. The solution was degassed and stirred while its temperature was raised at a rate of ∼2°C/min to 155°C and was held there for an additional 1 h. During heating, the color of the reaction mixture changed from blue to dark red, signifying the formation of CuNPs. Cu nanorods were obtained by the same route as CuNPs, except that 0.1 equivalent of dodecylammonium bromide was added as structure-directing surfactant. The Cu nanostructures prepared by this route could be further functionalized by exchanging weakly bound surfactants to tighter binding alkane-thiols. This functionalization allowed for the control of surface chemistry and solubility of CuNPs and CuNRs in different solvents, and yielded nanostructures that were stable in solution for prolonged periods of time. Noticeably, copper nanoparticles functionalized with positively charged thiols were stable in water for several months. Cu-containing particles could be precipitated from phenyl ether with ethanol and re-dispersed in toluene or hexane for further use [21].
Fig. 3.1.

TEM images of Cu nanoparticles prepared with different ratio of OAM to Cu(acac)2 (a–d). (e) UV–vis spectra of CuNPs in toluene: 1 freshly prepared CuNPs coated with OAM, 2 Cu/OAM NPs stored under argon for 10 days, 3 freshly prepared CuNPs protected with 1-undecanethiol 4 and 5 CuNPs coated with 1-undecanethiol and stored under argon for 10 and 20 days, respectively. (f) A representative TEM image of CuNPs coated with 1-undecanethiol. (g) UV–vis spectra of freshly prepared CuNPs in H2O (solid curve) and the same NPs stored in water for 2 months (dotted curve). (h) A representative image of Cu/TMA NPs. (i) The HRTEM image of alkylthiol-coated CuNPs (synthesized at χ = 100) (Reprinted with permission from [21]. Copyright 2010 American Chemical Society)
Fig. 3.2.

(a) SEM image of Cu nanorods, χ = 100, average aspect ratio, R ≈ 13 (average length/width 841.6 nm/63.5 nm). (b) TEM image of Cu nanorods, χ = 60, R ≈ 64 (average length/width 1,338 nm/21 nm). (c) HRTEM image of Cu nanorods, χ = 100; distance between two adjacent lattice planes is 2.2 Å. (d) TEM image of Cu nanorods coated with 1-undecanethiol after storing under atmosphere for several months. Scale bars (a) 400 nm, (b, d) 200 nm, and (c) 2 nm for the left and 200 nm for the right image (Reprinted with permission from [21]. Copyright 2010 American Chemical Society)
Copper Nanomaterials Supported on Organic Substrates
Metal nanoparticles (MeNPs) can be immobilized and coated onto surfaces for their better utilization. Since it is known that CuNPs may aggregate quickly in colloidal media, the extent of agglomeration can be effectively reduced by lowering the surface energy by adsorption of stabilizers such as polymers or surfactants present in the medium. The incorporation of smaller inorganic particles into larger polymers is also desirable in order to combine the key properties of both the materials. A few years ago, the group of C. Neckers reported on the synthesis of functionalized CuNPs/polymer composites. The preparation protocol was based on two steps: at first, functionalized CuNPs were obtained by a modification of the Brust’s procedure, introducing a polymerizable acrylic functionality into the NPs shell. Then, CuNPs were integrated into the polymer backbone by means of a specific cross-linking process, providing a way to control on the ionic release from the particles [22].
Colloidal CuNPs have been recently synthesized in a solution of hyperbranched polyamine (HBPA) by a reduction in the presence of NaBH4. Hence, hyperbranched polymer was simultaneously supporting the stabilization of metal colloidal solution, and preventing agglomeration and precipitation of the particles [23].
Weickmann et al. developed polymethyl-methacrylate (PMMA)/bentonite/Cu nanocomposites by an electroless copper-plating process involving aqueous Pd/bentonite dispersions that were first blended with a PMMA dispersion and then treated with an electroless plating bath. As a result, 14-nm copper nanospheres were selectively immobilized at the bentonite nano-platelet surface. Key feature of this technology is the in situ formation of bentonite-supported metal nanoparticles which are assembled at the surface of the cationic polymer latex. As a consequence, a fragile inorganic shell is obtained, which is ruptured during melt processing, producing very uniform fine dispersions of bentonite/metal hybrid nanoparticles. This approach was demonstrated for PMMA but offers several new preparation routes for other acrylic and styrene monomers [24].
Nanoparticulate hybrid systems derived from inorganic solids and carbon nanotubes (CNTs) were developed by Mohan and co-workers [25]. Chemically active surface and high-temperature stability are the basic attributes to use CNTs as the template for the growth of nanoparticles. Cu-grafted carbon nanotubes (Cu-MWCNTs) were prepared by a simple chemical reduction method divided into three steps. In the first step, acid groups were introduced on the carbon nanotube surface through sulphuric acid treatment, followed by the introduction of Cu ions in the second step. Finally, ions introduced on the surface were subjected to chemical reductions leading to the formation of Cu-MWCNTs [25].
Among the wide variety of polymer matrices, biopolymers are optimal candidates as CuNP-dispersing matrix, since they are readily available, inexpensive, environmentally friendly and fully compatible with scaling up industrial needs. Moreover, the biopolymer oxygen-rich functionalities and their affinity towards metals make them ideal candidates for the stabilization of nanoparticles [26, 27]. For example, agarose has been utilized to prepare bioactive composite films containing metal/semiconductor nanoparticles by introducing a metal/semiconductor precursor solution followed by a reducing agent, such as hydrazine hydrate, during the agarose gelation process. In a typical synthesis, agarose powder was dissolved in Luria-Bertani (LB) broth kept at 80°C with constant stirring. CuSO4 was added to this system at two different concentrations (about 3 and 6 μg of Cu per millilitre of LB broth), followed by the addition of N2H4 hydrate solution. The immediate appearance of wine red color was observed, indicating the formation of CuNPs which became faint upon solidification, and then was masked by the components of LB broth. The nanoparticles were trapped in the LB agarose matrix, which was then employed to check the NPs antibacterial activity, without further modification [26].
Cárdenas et al. have described the preparation and characterization of colloidal Cu nanoparticles/chitosan composite films (Fig. 3.3) by a solution-casting technique, assisted by microwave heating [28–30]. This method gives an appropriate nanoparticle size for its inclusion in chitosan matrix. The film-forming solution exhibited good dispersion and film-forming property due to the high density of amino and hydroxyl groups of chitosan, avoiding the aggregation of metallic particles. Cu nanoparticles incorporated in chitosan matrix improved the film barrier properties, decreasing the permeability to oxygen and water vapor. Furthermore, they increased the material protection against UV light [28, 29].
Fig. 3.3.

(a) Particle size distribution of colloidal Cu NPs, (b) TEM micrograph of colloidal Cu s, (c) UV–vis spectra of colloidal Cu NPs, (d) UV–vis spectra of films (Reprinted from [28], Fig. 3.1. With kind permission from Springer Science+Business Media)
Recently, Mary et al. proposed a novel cellulose-based fiber, obtained by periodate-induced oxidation of cotton cellulose fibres to give di-aldehyde cellulose, followed by covalent attachment of –NH2 group of chitosan through a coupling reaction [31]. This novel chitosan-bound cellulose fiber has been used for the immobilization of Cu2+ ions, producing a material the authors named “copper-bound chitosan-attached cellulose”, while, copper nanoparticles-loaded fibers (NCLCAC) were produced by borohydride-induced reduction of Cu2+ (Fig. 3.4) [31]. The same authors have also developed copper nanoparticles-loaded alginate–cotton fibers, which were prepared by immersing cotton fibers in aqueous solution of sodium alginate, followed by cross-linking of alginate chains in presence of Cu2+ ions; finally, the fibers were reduced with sodium borohydride [9].
Fig. 3.4.

Photograph showing (a) plain cotton cellulose fibers, (b) copper-bound chitosan-attached cellulose fibers, and (c) nanocopper-loaded chitosan-attached cotton fibers. Copyright permission requested (Reprinted with permission from [31]. Copyright 2009 John Wiley and Sons)
Very recently, a new method for preparing antibacterial cotton bandages has been developed by treating fabric surfaces with CuO NPs obtained via ultrasound irradiation [32]. The sonication process involved an in situ generation of CuO NPs and their subsequent deposition on fabrics in a one-step reaction. CuO-coated bandages were prepared as follows: a cotton bandage was added to an Cu(Ac)2 H2O solution of ethanol and then irradiated for 1 h with a high intensity ultrasonic Ti-horn. After adding the ammonium solution to the reaction cell, the color of the reaction mixture changed from light blue to deep blue and then became dark brown. The product was washed thoroughly, and then dried under vacuum. The as-prepared CuO NPs were thrown at the surface of the bandages by sonochemical microjets resulting from the collapse of the sonochemical bubble [32].
Copper-loaded carboxymethyl-chitosan (CMCS-Cu) nanoparticles have been successfully prepared by chelation under aqueous conditions [33]. CuSO4 was added to a CMCS solution under magnetic stirring, and the pH value of the solution was kept acidic. The resulting particles were purified by centrifugation and then extensively rinsed, re-dispersed in water and, lastly spray-dried before further use or analysis [33].
Fully Inorganic Copper Nanomaterials
Compared to organic hybrid antibacterial materials, fully inorganic antibacterial materials may offer several advantages, such as long-lasting action, stability (chemical, thermal, mechanical), simplified manufacturing and storage characteristics. The preparation of inorganic antibacterial materials has attracted interest in recent years, although it should be noted that – in the case of weak interactions of these agents with their supporting/dispersing media – this approach might suffer from NP leaching/releasing in aqueous media, which might give rise to nanotoxicology drawbacks.
A significant approach is that of synthesizing CuNPs in the presence of a supporting oxide, such as alumina, titania, and mesoporous silica. Based on the NP chemical stability, and on the interactions between CuNPs and the supporting oxide, the copper release properties can be delayed for such a long time that Cu-supported materials become attractive for antibacterial applications. Kim et al. reported on the synthesis and characterization of a well-dispersed Cu-SiO2 nanocomposite that was obtained by depositing copper nanophases onto preformed SiO2 NPs [34]. In this process, CuCl2 was added to a SiO2 NPs slurry under several mixing ratios and with or without making use of catalysts, at room temperature and under vigorous stirring. Finally, Cu-SiO2-1, Cu-SiO2-2, Cu-SiO2-3, and Cu-SiO2-4 nanocomposites were obtained [34].
Very recently, Wu et al. developed a novel biocompatible material composed of mesoporous copper-doped silica xerogels (m-SXCu) by a sol–gel process using tetra-ethoxy-orthosilicate and CuSO4·5H2O as precursors. Copper ions were demonstrated to be released from m-SXCu into the simulated body fluid at release rates depending on the nanocomposite composition (Fig. 3.5) [35].
Fig. 3.5.

Change of Cu concentration in the SBF soaking m-SXCu over time (Reprinted with permission from [35]. Copyright 2009 IOP Publishing Ltd)
A few years later, this simple, low cost method was used to prepare SiO2-Cu core–shell composites using SiO2 spheres as the supporting core and CuNPs as the shell [36]. Uniform spherical particles of SiO2 were fabricated according to an improved Stöber method. To deposit CuNPs on the surface of SiO2 spheres, the specified amounts of CuSO4·5H2O and Fe powder were added to SiO2 slurry. When the reaction was over, a fluid contained a brown-red precipitation was obtained. SiO2-Cu-1, SiO2-Cu-2, SiO2-Cu-3, and SiO2-Cu-4 were synthesized by adding different amounts of Fe powder [36].
Copper-based zeolites were synthesized by Petranovskii and co-workers [37]. The zeolitic raw mineral was ground and purified in order to remove the non-zeolitic mineral phases. Then, an ion exchange, a multistep process involving washing, drying and reduction in hydrogenn was carried out, in order to obtain dispersed metal species. The advantage of copper zeolites is their low cost and high permitted maximum concentration of copper accordingly to the World Health Organization (WHO) requirements. In fact, WHO have classified zeolite minerals as a function of their toxicity versus human health [37].
In a recent work of Stanić, the synthesis of copper-doped hydroxyapatite (HAP) nanopowders was done by an acid–base neutralization method [38]. This method was chosen because of its simplicity, the relatively inexpensive chemicals, the possibility of preparing pure products, and its suitability for industrial production. A required amount of CuO was dissolved in a solution of H3PO4, and the slow addition to suspension of Ca(OH)2 was applied to obtain a monophasic product. The slow reactant addition was found to yield pure, well-crystallized HAP, due to low supersaturation and avoidance of local inhomogeneity [38].
A new form of Au3Cu1 hollow nanostructure was prepared by the reaction of Cu nanoparticles with HAuCl4. Following a course of aging, the biomineral botallackite Cu2(OH)3Cl nanoflowers (Fig. 3.6) were developed with the aid of Au3Cu1 hollow nanostructures at room temperature. In a typical preparation of hollow nanospheres and nanoflowers, a laser-prepared Cu colloidal solution was added to HAuCl4 thus forming a greyish-blue dispersion of hollow nanospheres [39].
Fig. 3.6.

(a) SEM image of a single nanoflower. (b) TEM image of a single nanoflower (Reprinted with permission from [39]. Copyright 2006 American Chemical Society)
Finally, in a very recent work by Esteban-Tejeda et al., a low melting point soda-lime glass powder containing CuNPs was obtained following a simple and reliable bottom-up route starting from n-Cu sepiolite as source of the copper nanoparticles [40]. The glass was milled down and homogeneously mixed in isopropyl alcohol with the corresponding fraction of n-Cu sepiolite to obtain a copper-doped glass that was further treated, thus obtaining glass bars or pellets, that were finally milled down to <30 μm [40].
Electrochemical Syntheses
Electrochemical routes to metal nanoparticles (MeNPs) are of great interest since they allow for high purity products and for a strict control over the cluster morphology, without the need for chemical reductants.
In 2004, the so-called “sacrificial anode” method (proposed by Reetz in 1994 [41]) was applied in the authors’ laboratory to the electrochemical preparation of core–shell copper nanoparticles [42]. CuNPs were prepared using a small-scale electrolytic process, performed by using a three-electrode cell, equipped with a copper sheet as sacrificial electrode, a platinum sheet as cathode electrode, and Ag/AgNO3 0.1 M in acetonitrile as reference electrode. During such a process, when the applied potential is sufficiently high, the anode dissolves under the form of metal ions that are subsequently reduced at the cathode surface in the presence of proper surfactants, such as tetra-n-alkyl-ammonium salts, which stabilize the nanoparticle under the form of a core–shell structure in which the copper core is surrounded by quaternary ammonium ions (Fig. 3.7) [42–46]. Core–shell CuNPs were directly obtained as nanocolloidal dispersion in a solution of disinfecting quaternary ammonium species, and then they could be easily mixed to water-insoluble polymers which were ultrasonically dissolved in the electrolysis solution. Several dispersing polymers were tested, including polyvinyl-methyl-ketone (PVMK), polyvinyl-chloride (PVC), polyvinyldene-fluoride (PVDF),estel 1100, etc., as a function of the final application envisaged. The resulting CuNPs/polymer hybrid solutions – with different CuNPs loadings – were directly spin-coated onto proper substrates for further characterization or applications.
Fig. 3.7.

Nanoparticle with a core-shell structure in which the copper core is surrounded by quaternary ammonium ions
Moreover, despite unsupported copper colloids being extremely active against a wide range of bacterial pathogens [26], bioactivity experiments carried out on nanoparticles embedded in a polymer matrix showed that supported CuNPs may provide very high ion-release and eventually a significant efficiency in preventing microbial growth. Using supported materials in place of unsupported ones, affords a higher environmental compatibility for a wider range of applications, either as free-standing nanocomposites or as deposited thin nanostructured films. Lipophilic nanoparticles embedded into water-insoluble polymers cannot be released into the environmental media or when allowed in contact with aqueous solutions. Using different amounts of core–shell particles or properly choosing the stabilizing shell was shown to provide a way to finely select the concentration levels of released Cu ions. In fact, the stabilized structure of the CuNPs allowed a gradual and controlled copper ions release, when the nanocoatings were exposed to aqueous solutions (Fig. 3.8). The release extent of bioactive ions was demonstrated to be easily tuneable by a proper selection of preparation parameters, such as, for instance, the metal loading in the film. Noteworthy, the latter is a key aspect in order to kill or inhibit the growth of harmful species, without affecting the health of human beings [42, 47].
Fig. 3.8.

Copper release from CuNP-containing nanocomposites as function of time. Different CuNPs loadings in PVMK dispersing polymers were employed, relative weight percentages are reported on the right. Release curves are modelled as a first-order process (Reprinted with permission from [45]. Copyright 2005 American Chemical Society)
Physical/Mechanical Approaches
Physical approaches are frequently preferred to other routes when the simultaneous deposition of both nano-Cu and a proper dispersing medium (either organic or inorganic) is desired. The main difference between this approach and those described in the previous paragraphs is that the former does not necessarily provide NPs stabilization with a chemisorbed layer of surfactants or capping agents.
For example, the ion beam co-sputtering (IBS) technique can be employed to deposit different polymers and inorganic materials in an extremely controlled fashion, just by selecting the composition of appropriate targets and adjusting the IBS experimental conditions [48].
To the best of the authors’ knowledge, the first work aiming to deposit copper-based nano-antimicrobials by IBS was published by Ivanov-Omskii et al. in 2000 [49]. The authors reported on the modification of hydrogenated amorphous carbon (a-C:H) films with nanosized copper clusters by IB co-sputtering of copper and graphite targets in argon–hydrogen (80% Ar and 20% H2) DC magnetron plasma. The copper concentration in the growing film was varied within the range from 0 to 12 at.%, and it was controlled by changing the relative areas of graphite and copper targets. So, copper trapped into the a-C:H matrix was shown to deeply modify the structure and chemical characteristics of the layer [50].
In 2005, bioactive copper–fluoropolymer (Cu–CFx) nanocomposites were successfully deposited on different substrates by co-sputtering a Teflon target and a copper target with Ar+ ion beams at room temperature. The ion-beam properties (energy, current) and the growth rate ratio were chosen in order to obtain copper–flourocarbon composites with a copper volume fraction comprised in the interval 0 ≤ ϕ ≤ 0.25 [48]. The analytical characterization of these layers revealed that inorganic nanoparticles composed of Cu2+ species could be evenly dispersed in a branched fluoropolymer matrix at different copper/fluoropolymer concentration ratios. So, the IBS technique enabled the controlled and reproducible inclusion of inorganic NPs in a polymer-dispersing matrix, thus obtaining active coatings with tuneable properties [48].
Recently, Kelly et al. have co-deposited TiN/Cu nanocomposites with varying copper contents (0 to ~26 at.%) in a dual-pulsed magnetron sputtering system [49, 51]. The rig was equipped with two vertically opposed closed field unbalanced magnetrons. The power applied to the Ti target was kept constant for the deposition of TiN-based coatings, while the power applied to the Cu target was varied in order to obtain different coating compositions [49].
In 2010, Chang and co-workers proposed nanostructured Cr2N/Cu multilayer thin films that were deposited by the bipolar asymmetry reactive pulsed DC magnetron sputtering system [52]. Several multilayered thin films were deposited by alternately rotating the substrates from the plasma of Cr target to the plasma of Cu target. The target power values of Cr and Cu were adjusted to achieve a Cr2N/Cu thickness ratio of around 9:1. Different bi-layer periods (Λ) were achieved by controlling the substrate holding time in the plasma of Cr or Cu. In order to investigate the effects of Cu layer thickness on the antibacterial activity of the coatings with the same Λ, four thickness ratios of Cr2N/Cu layers were prepared [52].
In a study by Zhang et al. in 2006, copper was incorporated into the surface of polyethylene (PE) specimens by means of a plasma immersion ion implanter (PIII) [53]. One of the advantages of this approach is that low-energy Cu PIII can introduce a large amount of Cu into the polymer without causing too much damage to the polymer surface [53–55]. In a later study by the same authors, medical-grade PE specimens were implanted with Cu in a plasma immersion ion implanter equipped with a copper cathodic arc plasma source and nitrogen PIII was performed to change the structure of the implanted region of the substrate [56]. Compared to single plasma implantation processes, this dual PIII process (Cu/N2 PIII) provided a better control over the copper release rate and improved the long-term antibacterial properties of the Cu–PE nanomaterials, producing new polar unsaturated functional groups such as C = N and C ≡ N in the near surface of the polymer [56].
Ren and co-workers prepared copper oxide (CuO) nanoparticles using thermal plasma (TesimaTM) technology in 2009. The procedure allowed the preparation of CuO, Cu, and Cu2O nanoparticles with extremely high surface areas and unusual crystal morphologies [57]. On the other hand, drawbacks are represented by the cost of the processing apparatus and, most of all, by the potential risks related to handling copper-based nanoparticulate matter that could be unintentionally inhaled.
Finally, a low cost approach to nanoparticles and nanoparticulate coatings has been proposed by Yates et al., who used a flame-assisted chemical vapor deposition technique (FACVD) employing aqueous solutions of cupric nitrate as precursor, leading to nanostructured metal oxide thin films [58]. FACVD is a relatively simple atmospheric pressure chemical vapor deposition (CVD) technique that is compatible with both small volume batch and high volume continuous coating processes. Use of this method with low hazard aqueous solutions of simple metal salts can yield metal oxide thin films, which represents a major advantage in terms of precursor cost and environmental impact compared to alternative CVD methods [58].
Antimicrobial Activity
Copper shows an excellent antimicrobial activity against a wide range of microorganisms [1, 10], and such a property is greatly improved when Cu is properly nano-dispersed [59].
All papers reviewed in the previous section deal with the growth inhibition or killing effects of novel copper nanostructures towards several microorganisms. In this section, these studies have been classified according to the bioactivity towards three target classes: bacteria, fungi, and algae.
Most of the bacteria in the body are rendered harmless by the protective effects of the immune system, and a few are beneficial; however, some species of bacteria are pathogenic and may cause infectious diseases. Fungi have an essential role in the decomposition of organic matter and have fundamental roles in nutrient cycling and exchange, but many species produce bioactive compounds, including mycotoxins, that are toxic to animals including humans. Finally, the various sorts of algae play significant roles in aquatic ecology, even if some of them are common constituents of the biofilm formed during marine biofouling.
Genetic and biochemical studies have been conducted with microbial model systems including bacteria and yeast, establishing that cells have developed a sophisticated homeostatic mechanism to uptake copper [11, 12].
Microbial sensitivity to nanostructures has been found to be extremely different, depending on the microbial species and on the experimental set-up. Different methods that have been used to test the antimicrobial activity of copper nanomaterials are itemized as follows: disc diffusion test also defined zone of inhibition (ZoI), minimum inhibitory concentration (MIC), minimum bactericidal concentration (MBC) and counting the number of colony-forming units.
MIC is defined as the lowest concentration of a material that inhibits the growth of an organism; while MBC is defined as the lowest concentration of a material that inhibits the growth of an organism in batch cultures, this can be determined from broth dilution MIC tests by subculturing to agar media without antibiotics.
Hence, a quantitative comparison of the bioactivity effects of Cu-nano-antimicrobials is not possible in all cases, since the antimicrobial effectiveness was studied using different experimental parameters, such as methods, time of contact, and microorganism strain, as well as its initial concentration.
Antimicrobial Tests Against Bacteria
Bacteria are a large group of single-celled prokaryote microorganisms. There are two different types of cell wall in bacteria, called Gram-positive and Gram-negative. The names originate from the reaction of cells to the Gram stain, a test long-employed for the classification of bacterial species.
Gram-positive bacteria possess a thick cell wall containing many layers of peptidoglycan and teichoic acids, while Gram-negative bacteria have a relatively thin cell wall consisting of a few layers of peptidoglycan surrounded by a second lipid membrane containing lipopolysaccharides and lipoproteins.
Escherichia coli
Escherichia coli represents the most important model microorganism in studies on the antibacterial activity towards Gram-negative bacteria. Many papers mentioned in paragraph two deal with the assessment of the nano-antimicrobial activity against E. coli, tested using different protocols [9, 17, 25, 26, 31, 32, 34–36, 38, 40, 44, 45, 48, 52, 53, 57, 58].
Three different methods have been used to study the effects of CuNPs synthesized by Ruparelia and co-workers towards E. coli (four strains): disc diffusion test, MIC and MBC. The MIC and MBC values observed in this study are, respectively, in the range of 140–280 and 160–300 μg/mL. A good negative correlation was observed between the inhibition zone observed in disc diffusion test and MIC/MBC determined based on liquid cultures with the various strains (r 2 = −0.75) [17].
Copper oxide nanoparticles in suspension were used to determine the lowest bactericidal concentration required to prevent the growth of E. coli (NCTC 9001). As a result, a MBC value of 250 μg/mL was found [57], which is very similar to that observed by Ruparelia et al.
The disc diffusion test was also used to evaluate the antimicrobial properties of nanocopper-loaded fibers [31], nanocopper alginate–cotton cellulose fibers [9], Cu-SiO2 nanocomposite [34], SiO2-Cu composites [36], and copper-doped hydroxyapatite nanopowders [38].
The results of antibacterial action of nanocopper-loaded fibers, namely NCLCAC (2) and NCLCAC (4), clearly indicate that Petri dishes with plain fibers show dense populations of bacterial colonies. In contrast, Petri dishes supplemented with nanocopper-loaded fibers, NCLCAC (2) and NCLCAC (4), show less growth of colonies, as indicated by a clear zone of inhibition around the bunch of the amount of CuNPs present in the fibers which, in turn, depends upon the concentration of Cu2+ solution used for copper loading [31]. In another paper, the same authors showed that nanocopper alginate–cotton cellulose fibees efficiently inhibit bacterial growth (Fig. 3.9) [9].
Fig. 3.9.
Antibacterial activity of copper nanoparticles loaded alginate cotton cellulose fibres (Reprinted with permission from [31]. Copyright 2009 John Wiley and Sons)
The disk diffusion assay of Cu-SiO2 nanocomposites was determined by placing an 8-mm disk saturated with 50 μL of Cu-SiO2-1, Cu-SiO2-3, and Cu-SiO2-4 nanocomposite aqueous slurry onto an agar plate seeded with E.coli (ATCC 25922). After 24 h of incubation, the diameters of the inhibition zones were measured. The antibacterial activity of Cu-SiO2-1 was not detected, while the inhibition zones of SiO2-4 and Cu-SiO2-3 were determined as 11 and 15 mm. The antibacterial activities of the Cu-SiO2-3 nanocomposite were higher than those of Cu-SiO2-4 because Cu nanoparticles of the Cu-SiO2-3 nanocomposite were well formed and not aggregated on the surface of the SiO2 nanoparticle [34].
The antimicrobial activity of SiO2@Cu composites was examined against E. coli by two methods: paper disk agar diffusion assay and MIC. The inhibition zones of SiO2@Cu-2, SiO2-Cu-3, SiO2-Cu-4 were determined, respectively, as 16.8, 10.1 and 12.1 mm. SiO2-Cu-2 showed the best antibacterial properties and perfect core–shell structure. In order to calculate antimicrobial activity quantitatively, the MIC method was performed [36].
The antimicrobial activity of copper-doped hydroxyapatite nanopowders was tested against E. coli (ATCC 25922) by the so-called “agar diffusion” and “liquid challenge” methods. The diffusion technique was carried out by pouring agar into Petri dishes to form 4-mm-thick layers and adding a dense inoculum of the tested microorganisms in order to obtain semiconfluent growth. The results of antimicrobial disk diffusion tests showed that only CuHAP2 affects E. coli and that the average inhibition zone was 2 mm. The quantitative test was performed according to Radetić et al. [60] with some modifications. The results of the quantitative antimicrobial tests in liquid medium demonstrated that all metal-doped HAP samples show viable cells reduction [38].
Cioffi et al. carried out biological tests against E. coli on electrosynthesized copper nanoparticles dispersed in several polymers, and on IBS-deposited composites and copper fluoropolymer nanocomposites films. The screening of the antimicrobial activity was performed using a two-steps protocol. In the first step, properly diluted cultures containing the living cells were allowed to be in contact, under sterile conditions, with the nanostructured layers for a controlled interaction time. In the second step, a plate counter agar solid culture medium was poured onto the glass plates, which were subsequently incubated so that the vital cells, eventually present, could grow into colonies.
The microorganism colony presence was then evaluated, by counting the colony-forming units per Petri plate (CFU/mL). In the case of the CuNPs stabilized by tetra-butyl-ammonium-perchlorate (TBAP) and embedded in polymer matrixes like PVMK, PVC, and PVDF, it was observed that the samples always exerted clear biostatic activity on E. coli. Moreover, it was systematically observed that the CuNPs-PVMK films exhibited the strongest biostatic effect, while the least effective were the CuNPs-PVDF films.
The CFUs counted in the plates with the bare polymers and the polymers added with TBAP were comparable, within the experimental error, to the control experiment, indicating that neither the bare polymers nor the alkyl-ammonium salt exert any short- term biostatic activity on the growth of the microorganisms [45].
In contrast, in the case of the CuNPs stabilized by tetraoctylammonium chloride (TOAC) and embedded in polymer matrixes like PVMK, the ammonium salt gave rise to a strong growth inhibition effect, causing a significant decrease in the cellular growth. Interestingly, these nanocomposites were characterized by increased biological activity due to the simultaneous action of the TOAC and the embedded metal species [44].
Moreover, Cu-CFx coatings showed an even more striking disinfectant action towards E. coli thanks to the extremely high concentration of released copper species [48].
The viable E. coli cells were monitored by counting the number of colony-forming units, and the effect was quantitatively determined by the killing percentage for Cu-MWCNTs [25], CuO–cotton nanocomposites [32], Agarose–CuNPs composites [26], m-SXCu [35], Cr2N/Cu layer [52], Cu PIII PE samples [53], Cu PIII PE and Cu/N2 PIII PE samples [56].
Cu-MWCNTs were also investigated against bacteria, following the requirement of ISO 14729:2001(E) regulations. An amount of 20 μL of the bacterial suspension in USP phosphate buffer pH 7.2 was transferred to 1 mL of the prepared sample (21 μg of MWCNT-COOH/mL and 21 μg of Cu-MWCNT/mL) in a test tube. A series of tenfold dilutions in neutralizing broth were prepared and plated out in Trypticase Soy Agar. The plates were incubated at 37°C for 72 h and counted for colony-forming units. The results were expressed as:
![]() |
where Nsample represented the counts of survived bacterial inoculums in the neutralization broth containing 21 μL of Cu-MWCNTs or pristine MWCNTs. Pure MWCNTs exhibited a relatively low effect against E. coli bacteria (20 ± 2.5%) at the concentration level of the 21 μg/mL. Cu-MWCNTs exhibited a fairly good antimicrobial efficiency (~75%) as compared to pure CuNPs showing a killing percentage of about 52% [25].
CuO–cotton nanocomposites tested against E. coli led to the complete inhibition of cell growth [32].
Agarose–CuNPs composites at two different concentrations (3 and 6 μg of Cu per millilitre of LB broth) were employed to check the antibacterial activity of E. coli. Complete inhibition was observed even at the lower concentration (at about 3 μg of Cu per gram of composite gel) [26].
The antibacterial performances of m-SXCu against E. coli (ATCC 8723) were quantitatively determined using the same relationship used in the case of Cu-MWCNTs. m-SXCu showed good antibacterial activity against E. coli; for instance, the antibacterial rate reached 99% for the sample coded as “m-SXCu5” at 1 h, while it reached 99% for all m-SXCu samples at 24 h (Fig. 3.10). The antibacterial rate was improved with the increase of the amount of Cu, indicating that addition of Cu ions to m-SX enhanced its antibacterial activity [35].
Fig. 3.10.

Antibacterial rate of m-SX and m-SXCu against E. coli (Reprinted with permission from [35]. Copyright 2009 IOP Publishing Ltd)
The antibacterial tests of coatings with various bilayer periods (Λ) and different Cr2N/Cu thickness ratios were performed to evaluate the bactericidal ability towards E. coli (ATCC25922). A film attachment method (modifying the method JIS Z 2801:2000) was adopted for evaluating the antibacterial activity in this work. The effect was quantitatively determined using the same relationship used in the case of Cu-MWCNTs. Apparently, the coating antibacterial rate against each bacterium increased with increasing bilayer period and reached a maximum value of 100% at Λ = 20 nm, followed by a drastic decrease when the bilayer period increased to 40 nm. In order to investigate the effects of Cu layer thickness, the antibacterial rates of the coatings with fixed Λ = 12 nm and different Cr2N/Cu layer thickness ratios were also studied. As expected, the antimicrobial rate increased with increasing Cu layer thickness and reached a maximum value for the E. coli test of 100% at a Cr2N/Cu layer thickness ratio of 7:3[52].
Cu PIII PE samples were tested against E. coli (ATCC10536) suspensions with a concentration of 106 CFU/mL. The antibacterial performance was determined by the plate-counting method and the antibacterial effect was quantitatively determined using the same relationship used for Cu-MWCNTs. The effectiveness of the antimicrobial properties was as high as 96% [53].
In a more recent work, the antimicrobial properties of the Cu PIII PE and Cu/N2 PIII PE samples were studied at immersion times of 0, 14, 28 days. The tested microorganisms were E. coli suspensions with a concentration of 106 CFU/mL. The antibacterial performance was determined by the plate-counting method and the antibacterial effect was quantitatively evaluated using the same relationship of the previous paper [25]. Both Cu PIII PE and Cu/N2 PIII PE showed excellent antibacterial effects against E. coli. This was hypothesized to mainly stem from the surface-deposited Cu that can deliver immediate antimicrobial effects. After 14 days, the Cu PIII PE and Cu/N2 PIII PE samples still possessed good antibacterial performances against such a concentrated cell suspension, the antimicrobial effects against E. coli being higher than 70% and 80%, respectively [56].
Finally, the viable E. coli cells were monitored by counting the number of colony-forming units, and the effect was quantitatively determined by the logarithm of reduction for n-Cu sepiolite and the n-Cu-doped glass powder [40] on copper oxide thin films [58].
Biocide tests were performed to investigate the effect of the n-Cu sepiolite and the n-Cu-doped glass powder towards Escherichia coli JM 110; the nanomaterials were added over the cultures to obtain a final concentration of copper in each culture of 0.036 and 0.054 wt%. The survivals from each culture were counted every 24 h, after plating serial dilution. The effectiveness of the biocide agent was expressed as the logarithm of reduction, and it is defined as follows:
![]() |
where A is the average number of viable cells from inoculums control after 24 or 48 h and B is the average number of viable cells from the substance after 24 or 48 h. The activity against E. coli of n-Cu glass powder was very high (log η of 8.2 for the n-Cu glass powder versus 0.76 for the n-Cu sepiolite) after 48 h. Consequently, the MIC for the n-Cu glass powder as an antibacterial agent is <0.036 wt% [40].
Biocidal activity of copper oxide thin films on glass was determined by monitoring the survival rate of E. coli (ATCC 10536). The used test was a modification of the standard test described by BS EN 13, 697:2001 [61]. The films deposited at 400°C and with 30 passes were found to be highly bioactive and achieved high kill rates of >5 log reduction over 12 min. A much thinner sample of CuO, deposited at 400°C and with two passes, was also tested; in this case, the killing rate was much slower, taking 80 min for a 3 log reduction. The much slower growth rate was hypothesized to be correlated to a lower amount of CuO [58].
Staphylococcus aureus
Staphylococcus aureus represents the most frequently used target microorganism in studies on the antibacterial activity towards Gram-positive bacteria.
The antimicrobial properties of copper nanoparticles were investigated using S. aureus (three strains) by the disc diffusion test, MIC and MBC. The MIC and MBC values observed in this study are, respectively, 140 and 160 μg/mL [17].
Copper oxide nanoparticles in suspension were used to determine the MBC value for S. aureus EMRSA-16, S. aureus EMRSA-1, S. aureus 252, S. aureus (Golden) and S. aureus (Oxford) that were respectively equal to 1,000, 250, 1,000, 2,500 and 100 μg/mL [57].
Micro-MIC assays were performed for both Au3Cu1 hollow nanostructure and the derived Cu2(OH)3Cl nanoflowers. Both MIC50 and MIC90 were defined as the minimal concentrations of the nanoparticles to achieve 50% and 90% growth inhibition of the bacteria, respectively, as referenced to the non-treated control. As shown in Fig. 3.11, antimicrobial activities of both nanomaterials were observed. However, the hollow nanospheres showed stronger antibacterial effects than the nanoflowers with MIC50 values of 39.6 and 127.2 μg/mL, respectively [39].
Fig. 3.11.

Bacteria growth inhibition for S. aureus as referenced to the untreated control revealed dose-dependent antimicrobial activity of both hollow nanospheres (Au3Cu1) and nanoflowers (Cu2(OH)3Cl) (Reprinted with permission from [39]. Copyright 2006 American Chemical Society)
Bentonite-immobilized copper/PMMA hybrid nanocomposites exhibited only bacteriostatic behavior against S. aureus [24].
The antimicrobial activity of SiO2-Cu composites was examined not only against E. coli but also against S. aureus. The inhibition zones of SiO2-Cu2, SiO2-Cu3, and SiO2-Cu4 were determined, respectively, as 16.0, 9.5 and 11.2 mm; thus, SiO2-Cu2 showed the best antibacterial properties. The SiO2-Cu2 composites exhibited high efficiency for destruction of S. aureus with a MIC value of 0.8 mg/mL [36].
The antimicrobial activity of Cu-doped hydroxyapatite nanopowders was tested against S. aureus (ATCC 25923) by the agar diffusion method and the liquid challenge method in buffer solution with the same protocol used for E. coli. The results of antimicrobial disk diffusion tests showed no inhibition zone. The results of the quantitative antimicrobial tests in liquid medium demonstrated viable cell reduction by all the metal-doped HAP samples [38].
ZoI and a nitro-blue tetrazolium (NBT) redox dye were used against S. aureus to determine the antimicrobial effectiveness of TiN/Cu nanocoatings following incubation. For the NBT assays, colony-forming units were counted following submersion in the NBT dye for 5 h. For the ZoI assays, the zones of inhibition from the surface were measured using an electronic micrometer. For the NBT assays, significant reduction in the number of viable cells was observed with increasing Cu content, compared to the ‘pure’ nitride surfaces, while no zones of inhibition were observed. This could be explained by considering that the latter assay is sensitive to ion leaching from the surface into the agar [49].
In a recent work, Cu nanoparticles/chitosan composite films were tested against S. aureus (ATCC 25923). A standard plate count method on Mueller–Hinton Agar was used to determine the concentration of bacteria capable of reproducing. The composite film was effective in reducing microbial concentration in the bulk fluid for the microorganism tested. Cell wall deformation is related to the cytoplasmic volume decrease (Fig. 3.12) and the detrimental structural change was the result of the cell shrinkage [28].
Fig. 3.12.

(a) TEM micrograph of thin section of untreated S. aureus. (b) TEM micrograph of thin section of S. aureus treated with composite film. (c, d) TEM micrograph of deposition onto copper grid of S. aureus treated with composite film (Reprinted from [28], Fig. 3.6. With kind permission from Springer Science+Business Media)
CuO–cotton nanocomposites were also tested against S. aureus. Treatment for 1 h with the coated cotton led to the complete inhibition of cell growth [32].
The antibacterial performance of m-SXCu against S. aureus (AATCC 6538) was determined by the method of plate counting. Similar results to E. coli were obtained, since the antibacterial rate of m-SXCu increased with the increase of Cu amounts at 1 h as shown in Fig. 3.13 [35].
Fig. 3.13.

Antibacterial rate of m-SX and m-SXCu against S. aureus (Reprinted with permission from [35]. Copyright 2009 IOP Publishing Ltd)
In the authors’ laboratories, TBAP-capped CuNPs were dispersed in several polymers and employed in biological experiments against S. aureus and Lysteria monocytogenes following the experimental protocol previously described. A similar approach was also used for Cu-CFx ultra-thin coatings. In all cases, a clear correlation was found between ion release properties and bioactivity of these nanomaterials [45, 48].
The antibacterial activity of 1,000-nm carboxymethyl-chitosan (CMCS) particles and of ~100-nm copper-loaded CMCS particles were evaluated against S. aureus by the vibration method. Results showed that the antibacterial efficiency of nanoparticles reached 99%, which is much more efficient than the 68.9% of the normal 1 of 1,000 nm and the 6.1% of CMCS [33].
Antibacterial tests of coatings with various bilayer periods and different Cr2N/Cu thickness ratios were performed against S. aureus and showed that the antibacterial rate reaches 100% at Cr2N/Cu layer thickness ratios of 5:5 [52].
Cu PIII PE samples were also tested against S. aureus (ATCC 6538) and their antibacterial effect was as high as 86% [53].
Finally, the antimicrobial activity of Cu-SiO2 nanocomposite was measured by the paper disk diffusion method against S. aureus (ATCC 25923). Only the antibacterial activity of Cu-SiO2-3 and Cu-SiO2-4 was detected [34].
Gram+ and Gram− Bacteria
In view of real-life applications, copper nanomaterial antimicrobial properties were tested towards several bacteria.
Bacillus subtilis (three strains), although it is not a human pathogen, may contaminate food and causes food poisoning and, as such, it has been chosen as a target species [17]. Tests on this microorganism were carried out by MIC and MBC approaches. The MIC and MBC values observed in this study are, respectively, 20 and 40 μg/mL. As a result, copper nanoparticles have been hypothesized to show a great affinity to surface-active groups of B. subtilis.
Glass-supported copper oxide thin films were also tested against Staphylococcus epidermidis (NCTC 11047). This bacterium was chosen since it can grow on plastic devices, such as intravenous catheters, and on medical prostheses placed within the body. Interestingly, the rate of kill exerted by the afore-mentioned Cu-nano-antimicrobials was similar for both E. coli and S. epidermidis. Generally, Gram-positive bacteria such as S. epidermidis are considered to be more resistant than Gram-negative bacteria such as E. coli, but in this case there was little difference [58]. Not only copper oxide thin films on glass but also copper oxide nanoparticles in suspension were used to determine the lowest bactericidal concentration required to prevent the growth of two strains of S. Epidermidis. The MBC value for S. Epidermidis SE-51 and SE-4 was 2,500 μg/mL. Moreover, the MBC value was 5,000 μg/mL for Proteus spp. [57].
Cu nanoparticles/chitosan composite films were also tested against Salmonella enterica serovar Typhimurium with the same protocol used for S. aureus. The cell wall of S. Typhimurium is very rough due to the cell wall components, which are also possibly cross-linked, resulting in heterogeneous surfaces. Treated cells with composite film appeared smooth, collapsed and cracked, and markedly shrank [28].
Very recently, copper-containing nanomaterials such as TiN/Cu nanocoatings, Cr2N/Cu multi-layered thin films and copper oxide nanoparticles were tested against Pseudomonas aeruginosa. Usually, this microorganism infects the pulmonary and urinary tracts, as well as burns, wounds, and also causes other blood infections. As a consequence, P. aeruginosa is a target species of considerable applicative interest. In the case of TiN/Cu films, similar considerations to S. aureus could be done about the biological results as reported in Sect. 3.1.2 [49]. In the case of Cr2N/Cu multi-layered thin films, the antibacterial rate reached 100% at a Cr2N/Cu layer thickness ratio of 3:7 [52]. Finally, copper oxide nanoparticles in suspension were used to determine the lowest bactericidal concentration required to prevent the growth of P. aeruginosa; the resulting MBC value was 5,000 μg/mL [57].
The activity of the Cu-SiO2 nanocomposite against Enterobacter cloacae (ATCC 29249), which is associated with infections of the urinary and respiratory tracts, was measured by the paper disk diffusion method [34].
The antimicrobial effect of the n-Cu sepiolite and the n-Cu-doped glass powder was also performed against Micrococcus luteus, which colonizes the human mouth, mucosae, oropharynx and upper respiratory tract. For a copper content in the cultures of 0.036 wt%, n-Cu sepiolite and n-Cu glass powder showed similar bioactivity (log η of 3.36 versus 3 after 48 h of biocide test). However, at an increasing content of copper in the cultures, the biocide activity of n-Cu glass powder was significantly higher [40].
In the authors’ laboratories, tests on the bioactivity of CuNPs-Estel nanomaterials were recently performed against Arthrobacter histidinolovorans (ATCC 11442), yielding a complete inhibition of the microorganism growth [46]. The importance of this evidence relies in the perspective application of Cu/Estel nano-antimicrobials to the field of the cultural heritage. The proposed material behaved as a multifunctional coating, capable of combining the antimicrobial properties of nanostructured copper with those of the formulations applied to the restoration of stone artworks.
Copper NPs/polymer composites synthesized by Neckers and co-workers were tested against cyanobacterial strains of Synechocystis sp. PCC 6803 (freshwater) and Synechococcus sp. PCC 7002 (marine). The Cu NP/polymer composite pellets were immersed in flasks containing the growing cells at the start of the culture period. Cell growth of the cyanobacteria was correlated with absorbance measured at 24-h intervals at 680 nm. All tested Cu NP species exhibited good antibacterial activity, especially when NPs were chemically attached to the polymer backbone [22].
Antimicrobial Tests Against Fungi
The fungus kingdom encompasses an enormous diversity of taxa with varied ecologies, life cycle strategies, and morphologies ranging from single-celled aquatic chytrids to large mushrooms.
So far, more than ten papers have dealt with the bioactivity of the novel copper nanostructures towards fungi. The different studies on each nanomaterial are itemized and classified in the following in terms of the function of the target microorganism.
Among the different species of fungi, Saccharomyces cerevisiae is a model organism for studying the antifungal activity of nanomaterials. In 2004 and following years, we choose this microorganism to test copper nanoparticles/polymer composites and copper fluoropolymer nanocomposites films. The screening of the antifungal activity was performed using a two-step protocol, as previously described. The microorganism colony presence was then evaluated, by counting the colony-forming units per Petri plate (CFU/mL).
In the case of the CuNPs stabilized by TBAP and embedded in polymer matrixes like PVMK, PVC, and PVDF, it was observed that the samples always exerted clear biostatic activity on the yeast cell growth. Moreover, it was systematically observed that composites exerting the highest release of Cu ions exhibited the strongest biostatic effect [45]. The results clearly showed that the higher the nanoparticle loading, the lower the number of residual CFU; i.e., the stronger the antifungal effect (Fig. 3.14) [42].
Fig. 3.14.

The left Y axis reports the amount of the CFU/mL for seven different PVMK nanocomposites loaded with different bulk concentrations of CuNPs. The right Y axis reports the copper concentration released by the nanocomposites in the culture broth after 4 h exposure (Reprinted with permission from [42]. Copyright 2004, American Institute of Physics)
Similar results were obtained for Cu-CFx coatings. Higher loadings of unstabilized metal nanoparticles resulted in higher copper surface availability and in a much higher release of copper ions; eventually, this gave rise to a significantly increased bioactivity [48].
Finally, in the case of CuNPs stabilized by TOAC and embedded in polymer matrixes like PVMK, it was observed that the ammonium salt itself was strongly inhibiting the fungi growth. As a consequence, Cu/TOAC/polymer hybrid materials showed an increased biological activity, thanks to synergistic action of the quaternary ammonium species and of copper ions [43, 44].
Effective antifungal activity of hyperbranched polyamine CuNPs, Cu-SiO2 nanocomposites, SiO2-Cu and copper-doped hydroxyapatite nanopowders were observed against Candida albicans fungus, which can be a pathogenic agent, causing candidiasis in the oral cavity, the esophagus, the gastrointestinal tract, the urinary bladder and the genital tract. The results of antifungal studies clearly demonstrated that the colloidal hyperbranched polyamine/CuNPs inhibited the growth of C. albicans even at very low total concentrations of copper (1.4 g/100 L) [23].
The antimicrobial activity of the Cu-SiO2 nanocomposite was measured by the paper disk diffusion method. The disk diffusion assay was determined by placing an 8-mm disk saturated with 50 μL of several Cu-SiO2 nanocomposite aqueous slurries onto an agar plate seeded with C. albicans and Penicillium citrinum. The latter produced ochratoxin and citrinin which may cause growth retardation, hepatic necrosis and nephropathy. After 24 h of incubation, the diameters of the inhibition zones were measured and selected samples were shown to be active against C. albicans [34].
In a recent paper, the antimicrobial activity of SiO2-Cu composites was examined by two methods, namely paper disk agar diffusion assay and MIC. The ZoI comprised between 9 and 10.6 mm, as a function of the amount of copper on the SiO2 surface. In order to calculate antimicrobial activity quantitatively, the MIC method was performed. The SiO2-Cu core–shell composite was dissolved in ultrapure deionized water to form colloidal solutions with different SiO2-Cu concentrations. High efficiency for the destruction of C. albicans was obtained at nano-antimicrobial concentrations of 0.9 mg/mL [36].
The antimicrobial activity of copper-doped hydroxyapatite nanopowders was tested against yeast C. albicans (ATCC 24433) by the agar diffusion method and the liquid challenge method in buffer solution. The diffusion technique was carried out by pouring agar into Petri dishes to form 4-mm-thick layers and adding a dense inoculum of the tested microorganisms in order to obtain semiconfluent growth. The results of antimicrobial disk diffusion tests showed that only some samples affected C. albicans and the average inhibition zone was 3 mm. The results of the quantitative antimicrobial tests in liquid medium demonstrated that all metal-doped HAP samples show viable cell reduction [38].
Low-polydispersion copper nanoparticles and nanorods exhibited antifungal properties against Stachybotrys chartarum, which is a common indoor house mold that has been linked to various health effects and the “sick building syndrome”. The disk diffusion assay and MIC tests were used. In the first assay, the radii, r, of the inhibition zone surrounding CuNP reservoirs depended on the concentration of the nanoparticles (Fig. 3.15). Following the standard procedure, these radii were fitted to the solution of the one-dimensional, radial diffusion equation:
![]() |
where r 0 = 5 mm is the radius of the NP reservoir, D is the diffusion constant of CuNPs/Cu2+, t is the time, and c 0 is the critical NP concentration required to inhibit any growth of the fungus. Rearranging this equation and plotting
![]() |
gave the critical concentration (from the y-intercept) of 55.46 μM in terms of Cu atoms, which is close to the minimum inhibitory concentration of 40 μM determined by the MIC assay. This MIC value is lower than the Stachybotrys chartarum MIC values reported for carneic acid (75 μM, 25 μg/mL), penicillin G (299 μM, 100 μg/mL), or itraconazole (142 μM–142 mM; 0.1–100 mg/mL) but higher than the 2.5 μM (3.12 μg/mL) [43] for actinomycin D (which, however, is highly toxic) [21].
Fig. 3.15.

Antifungal and catalytic properties of CuNPs. Radii of the inhibition zones plotted as a function of CuNP concentration. Critical inhibitory concentration 55.46 μM is estimated from the y-intercept (Reprinted with permission from [21]. Copyright 2010 American Chemical Society)
To investigate the effect of the n-Cu sepiolite and the n-Cu-doped glass powder on Issatchenkia orientalis, the nanomaterials were added over the culture to obtain a final concentration of copper in each culture of 0.036 and 0.054 wt%, respectively. The survivals from each culture were counted every 24 h after plating serial dilution. No activity was detected for the n-Cu sepiolite, while n-Cu glass powder was active at a Cu concentration of 0.054 wt%. This activity could be explained by considering the synergistic effect of n-Cu with Ca2+ lixiviated from the glass [40].
In 2000, the fungistatic action of a-C:H:Cu films was tested towards five species of fungi: Aspergillus niger (giving rise to aspergillosis upon spore inhalation); Chaetomium globosum (which is a cause of infections in humans); Cladosporium cladosporioides and Epicoccum nigrum (which are fungal plant pathogens); and Pestalotia heteromorpha. In these tests, samples were inoculated with fungi spores in distilled water (pH = 6.8), and stored in closed chambers for 21 days at T = 27°C and 100% humidity. Quantitative estimation of fungal growth, based on the so-called coefficients of biodeterioration (K), was expressed as the ratio between the area covered by fungi and the whole area of the analyzed field. No pathological fungal growth was detected on a-C:H:Cu films containing 9 at.% of copper [50].
Three species of black fungi (Cladosporium cladosporoides, Phaeococcomyces chersonesos, Ulocladium chartarum), isolated from marble were used to demonstrate fungicide action of Cu-based zeolites. Zeolite powder concentrations were in a range from 0.005 to 0.5 g/cm2 for each series of samples. Marble samples were exposed in closed chambers for 21 days at T = 27°C and 100% humidity. Morphological characteristics, mycelia patterns formation on solid media, growth rate, and fungal biomass amount in stationary growth phase were used for the characterization of fungicide activity of zeolite samples. Minimal inhibiting concentration of zeolite powder, sufficient for preventing fungal growth, lay in the range 0.05–0.1 g/cm2 and depended on the fungal strain [37].
Antimicrobial Tests Against Algae
Algae are a large and diverse group of simple, typically autotrophic organisms, ranging from unicellular to multicellular forms. Among the referenced studies on Cu-nano-antimicrobials, only the group of Neckers has chosen strains of green algae and diatoms to detect the biological activity of different functionalized copper NPs/polymer composites. A freshwater green alga, Chlamydomonas sp. strain CD1 Red, and the marine diatom, Phaeodactylum tricornutum CCMP 1327, were used as test organisms. Cu NP/polymer composite pellets were immersed into the flasks containing the growing cells at the start of the culture period. Two controls were established: the culture without any polymers or biocides, and the polymer lacking any copper particles. The latter was important to probe the effects of the polymer matrix or the irradiated photo-initiator on cell growth. Cell growth of the green algae was correlated with absorbance measured at 24-h intervals at 680 nm. The cell growth of the diatoms was monitored daily by measuring in vivo chlorophyll fluorescence (λex = 436 nm; λem = 680 nm). The antimicrobial activity of the acrylated copper nanoparticles developed by Neckers’ group matched well with conventionally used biocides [22].
Applications of Antimicrobial Copper Nanomaterials
Despite the difficulty of a quantitative comparison regarding the biological activity of the copper-based nanomaterials, the results mentioned in the previous paragraphs demonstrate the great potentialities of these novel nanostructures as efficient biocide agents with a widespread action.
Moreover, the large number of possible approaches to the synthesis of these nanostructures are reasonable to envisage a great development of this research field thanks to the perspective growth of their real-life applications.
The use of stabilized and/or polymer-dispersed CuNPs provides better control over ion release properties, especially when NPs are chemically interacting with the polymer backbone [22], or when they are further stabilized, due to a tuneable core–shell structure [47]. Biological activity is not compromised by the use of controlled releasing of Cu-nanomaterials; on the contrary, we have recently demonstrated that these materials may have a great value for the development of antibacterial paints and coatings for household materials, textiles, biomedical devices, hospital and food storage equipment, etc. [47]. Thus, metal-polymer nanocomposites can be a valid option for such purposes because of the highly dispersed nature of the metal releasing-clusters and a large nanoparticles–polymer interface area that ensures high reactivity. Advanced antifungal coating materials, such as hyperbranched polyamine/Cu nanoparticles, low-polydispersion copper NPs and NRs, functionalized CuNPs and Cu-grafted carbon nanotubes, are very important innovations for a number of biotechnological applications [21, 22, 25].
Microscopic fungi play an important role in the deterioration of the cultural heritage; stone monuments represent an important part of this heritage. Due to their prevalently outdoor location, they are generally subject to a complex series of weathering and decay processes causing aesthetic, biogeophysical and biogeochemical damages. The most recent approaches to the development of novel antimicrobial agents are based on the application of Cu-zeolites, amorphous hydrogenated carbon films doped with copper, and CuNPs mixed with Estel 1100, commonly used as a water repellent/consolidant [37, 46, 50].
The porous nature of agarose polymer films coupled with CuNPs can find application in antimicrobial membrane filters and coatings. This kind of nanomaterial can be utilized in food packaging, sanitation and fabrics, because of the ability of agarose to form transparent gels and films [26].
Similarly, biopolymer films, such as chitosan, modified with CuNPs were demonstrated to be effective in reducing the fluid concentration of two microorganisms affecting food quality and could therefore be used to improve food quality and extend its shelf life [28].
Metal nanoparticle-loaded fibres (particularly cotton cellulose fibers) could be used in a number of biomedical and textile applications such as medical devices, burn/wound dressings, healthcare (including disposables), personal care products, veterinary, military and bio-defence, protective suits, clothing, etc. [31, 32].
Among the fibrous products, alginate-based products are currently the most popular ones used in developing antimicrobial agent-releasing systems or textile materials. In particular, copper nanoparticle-loaded composite fibers show fair mechanical strength, excellent Cu2+-releasing capacity due to their ion-exchange property and a high degree of antibacterial activity against the model bacterium E. coli [9].
An inorganic antimicrobial agent incorporated into an organic biomedical polymer can significantly increase its usefulness in medicine [53, 56], and even inorganic nanocomposites such as mesoporous copper-doped silica xerogels have been proposed as biomedical materials (for instance, in the treatment of traumatic wounds), because of their excellent in vitro and in vivo biocompatibility [35]. Moreover, the application of Cr2N/Cu multilayered coating on the surfaces of implanted medical devices seems particularly promising [52].
Metal-doped hydroxyapatite nanopowders can be applied as antimicrobial materials of various purpose, such as for bone defects and implant coating in orthopaedic surgery, for the treatment of skin infections, for the treatment of microbiologically polluted water, and as polymer additives [38].
CuO nanoparticles were demonstrated to be effective in killing a range of bacterial pathogens involved in hospital infections. Notably, hospitals and transport are two key fields that offer great opportunities for the use of copper nano-antimicrobials to prevent infections and pandemic diseases. Wall coatings, equipment, clothing, seats and bedding are all potential risk areas for the spread of infections, and this could be particularly important in the case of microorganisms that have developed a resistance towards conventional disinfecting agents and antibiotics [57].
The number of potential applications is evidently enormous, and it is expected to grow further, considering that other metals – such as silver and zinc – can be used for similar purposes, and multi-metal nanomaterials could also be developed.
Conclusions
A selection of recent studies dealing with the development of novel antimicrobial copper nanomaterials and their applications has been reviewed in the present chapter.
The referenced routes to copper nano-antimicrobials offer different advantages. Wet chemical syntheses are very simple and they are presently the most diffused methods. Electrochemical processes do not require chemical reductants and hence they allow for a high purity of products and for a tight control over the cluster morphology. Physical/mechanical approaches do not involve surfactants or capping agents, but they might result in poly-disperse NPs. Therefore, the choice of the appropriate route is a function of the final application of the antimicrobial nanomaterials.
Bulk copper materials provide themselves an excellent antimicrobial activity against a wide range of microorganisms (such as bacteria, fungi, algae, and viruses), and such a property is greatly improved when copper is properly nano-dispersed.
In CuNP bioactivity experiments, the Gram-negative E. coli, the Gram-positive S. aureus, and the yeast S. cerevisiae are the most common microorganisms employed to test the biological activity of antimicrobial agents. It should be noted, however, that, aiming at real-life applications, Cu-nanoantimicrobial properties have often been tested towards several other species. No matter the microorganism type, Cu-nano-antimicrobials proved to effectively kill it or to significantly inhibit its growth.
It may be useful to create a sort of index of the antimicrobial effectiveness of the nanomaterials classified in this chapter. However, a quantitative comparison of the bioactivity effects of Cu-nano-antimicrobials demonstrated in the existing literature is actually impossible. The referenced studies have been carried out by using different experimental parameters, and frequently the studied microorganisms belonged to different classes.
Thanks to the large number of possible approaches to these nanostructures and to the prospective growth of their real-life applications, it is reasonable to envisage a great development of this research field. The main limitations seem to reside in the need for carefully assessing any possible nano-toxicology effect related to the exposure of humans to brand new nanomaterials with unknown properties. Until now, confinement of the Cu-containing nanophases into insoluble dispersing polymer networks inhibiting NP leaching phenomena appears to be one of the most promising ways to solve these issues.
Contributor Information
Nicola Cioffi, Email: cioffi@chimica.uniba.it.
Mahendra Rai, Email: mkrai@rediffmail.com.
Daniela Longano, Email: longano@chimica.uniba.it.
References
- 1.SCI Finder ScholarTM, American Chemical Society
- 2.Fang M, Chen JH, Xu XL, Yang PH, Hildebrant HF. Antibacterial activities of inorganic agents on six bacteria associated with oral infections by two susceptibility tests. Int J Antimicrob Ag. 2006;27:513–517. doi: 10.1016/j.ijantimicag.2006.01.008. [DOI] [PubMed] [Google Scholar]
- 3.Trapalis CC, KokkOris M, Perdikakis G, Kordas G. Study of Antibacterial Composite Cu/SiO2 Thin Coatings. J Sol-Gel Sci Techn. 2003;26:1213–1218. doi: 10.1023/A:1020720504942. [DOI] [Google Scholar]
- 4.Pal S, Tak YK, Song JM. Does the Antibacterial Activity of Silver Nanoparticles Depend on the Shape of the Nanoparticle? A Study of the Gram-Negative Bacterium Escherichia coli. Appl Environ Microb. 2007;73:1712–1720. doi: 10.1128/AEM.02218-06. [DOI] [PMC free article] [PubMed] [Google Scholar]
- 5.Sambhy V, MacBride MM, Peterson B, Sen A. Silver bromide nanoparticle/polymer composites: dual action tunable antimicrobial materials. J Am Chem Soc. 2006;128:9798–808. doi: 10.1021/ja061442z. [DOI] [PubMed] [Google Scholar]
- 6.Holt KB, Bard AJ. Interaction of silver(I) ions with the respiratory chain of Escherichia coli: an electrochemical and scanning electrochemical microscopy study of the antimicrobial mechanism of micromolar Ag+ Biochemistry. 2005;44:13214–13223. doi: 10.1021/bi0508542. [DOI] [PubMed] [Google Scholar]
- 7.Kawashita M, Tsuneyama S, Miyaji F, Kokubo T, Kozuka H, Yamamoto K. Antibacterial silver-containing silica glass prepared by sol-gel method. Biomaterials. 2000;21:393–398. doi: 10.1016/S0142-9612(99)00201-X. [DOI] [PubMed] [Google Scholar]
- 8.Faundez G, Troncoso M, Navarrete P, Figueroa G. Antimicrobial activity of copper surfaces against suspensions of salmonella enterica and campylobacter. BMC Microbial. 2004;4:19–25. doi: 10.1186/1471-2180-4-19. [DOI] [PMC free article] [PubMed] [Google Scholar]
- 9.Mary G, Bajpai SK, Chand N. Copper Alginate-Cotton Cellulose (CACC) Fibers with Excellent Antibacterial Properties. J Eng Fiber and Fabr. 2009;4:24–35. [Google Scholar]
- 10.Grass G, Rensing C, Solioz M. Metallic Copper as an Antimicrobial Surface. App Environ Microb. 2011;77:1541–1547. doi: 10.1128/AEM.02766-10. [DOI] [PMC free article] [PubMed] [Google Scholar]
- 11.Peña MMO, Koch KA, Thiele DJ. Dynamic Regulation of Copper Uptake and Detoxification Genes in Saccharomyces cerevisiae. Mol Cell Biol. 1998;18:2514–2523. doi: 10.1128/mcb.18.5.2514. [DOI] [PMC free article] [PubMed] [Google Scholar]
- 12.Halliwell B, Gutteridge JMC. Oxygen toxicity, oxygen radicals, transition metals and disease. Biochem J. 1984;219:1–14. doi: 10.1042/bj2190001. [DOI] [PMC free article] [PubMed] [Google Scholar]
- 13.Nyden M, Fant C (2006) PCT Int. Appl. 27 pp. Application: WO 2006-SE318 20060313
- 14.Stupp SI, Hartgerink JD, Beniash E (2003) PCT Int. Appl. 54 pp. Application: WO 2003-US4779 20030218
- 15.Lin J, Yang CY, Chou CC, Su HL, Hung TJ (2009) U.S. Pat. Appl. Publ. 27 pp. Application: US 2008–253037 20081016
- 16.Cioffi N, Ditaranto N, Torsi L, Sabbatini L (2009) Approaches to synthesis and characterization of spherical and anisotropic copper nanomaterials. In: Challa Kumar (ed) Metallic Nanomaterials, Wiley-VCH, Weinheim (Germany)
- 17.Ruparelia JP, Chatterjee AK, Duttagupta SP, Mukherji S. Strain specificity in antimicrobial activity of silver and copper nanoparticles. Acta Biomat. 2008;4:707–716. doi: 10.1016/j.actbio.2007.11.006. [DOI] [PubMed] [Google Scholar]
- 18.Xiong J, Wang Y, Xue QJ, Wu XD. Synthesis of highly stable dispersions of nanosized copper particles using L-ascorbic acid. Green Chem. 2011;13:900–904. doi: 10.1039/c0gc00772b. [DOI] [Google Scholar]
- 19.Ding LP, Fang Y. The study of resonance Raman scattering spectrum on the surface of Cu nanoparticles with ultraviolet excitation and density functional theory. Spectrochim Acta A. 2007;67:767–771. doi: 10.1016/j.saa.2006.08.030. [DOI] [PubMed] [Google Scholar]
- 20.Panigrahi S, Kundu S, Ghosh SK, Nath S, Praharaj S, Basu S, Pal T. Selective one-pot synthesis of copper nanorods under surfactantless condition. Polyhedron. 2006;25:1263–1269. doi: 10.1016/j.poly.2005.09.006. [DOI] [Google Scholar]
- 21.Wei Y, Chen S, Kowalczyk B, Huda S, Gray TP, Grzybowski BA. Synthesis of Stable, Low-Dispersity Copper Nanoparticles and Nanorods and Their Antifungal and Catalytic Properties. J Phys Chem C. 2010;114:15612–15616. doi: 10.1021/jp1055683. [DOI] [Google Scholar]
- 22.Anyaogu KC, Fedorov AV, Neckers DC. Synthesis, Characterization, and Antifouling Potential of Functionalized Copper Nanoparticles. Langmuir. 2008;24:4340–4346. doi: 10.1021/la800102f. [DOI] [PubMed] [Google Scholar]
- 23.Mahapatra SS, Karak N. Hyperbranched Polyamine/Cu Nanoparticles for Epoxy Thermoset. J Macromol Sci. 2009;46:296–303. doi: 10.1080/10601320802637375. [DOI] [Google Scholar]
- 24.Weickmann H, Tiller JC, Thomann R, Mülhaupt R. Metallized Organoclays as New Intermediates for Aqueous Nanohybrid Dispersions, Nanohybrid Catalysts and Antimicrobial Polymer Hybrid Nanocomposites. Macromol Mater Eng. 2005;290:875–883. doi: 10.1002/mame.200500153. [DOI] [Google Scholar]
- 25.Mohan R, Shanmugharaj AM, Hun RS. An efficient growth of silver and copper nanoparticles on multiwalled carbon nanotube with enhanced antimicrobial activity. J Biomed Mater Res B. 2011;96:119–126. doi: 10.1002/jbm.b.31747. [DOI] [PubMed] [Google Scholar]
- 26.Datta KKR, Srinivasan B, Balaram H, Eswaramoorthy M. Synthesis of agarose–metal/semiconductor nanoparticles having superior bacteriocidal activity and their simple conversion to metal–carbon composites. J Chem Sci. 2008;120:579–586. doi: 10.1007/s12039-008-0088-y. [DOI] [Google Scholar]
- 27.Liu JC, He F, Durham E, Zhao D, Roberts CB. Polysugar-stabilized Pd nanoparticles exhibiting high catalytic activities for hydrodechlorination of environmentally deleterious trichloroethylene. Langmuir. 2008;24:328–336. doi: 10.1021/la702731h. [DOI] [PubMed] [Google Scholar]
- 28.Cárdenas G, Díaz JV, Meléndrez MF, Cruzat CC, Cancino AG. Colloidal Cu nanoparticles/chitosan composite film obtained by microwave heating for food package applications. Polym Bull. 2009;62:511–524. doi: 10.1007/s00289-008-0031-x. [DOI] [Google Scholar]
- 29.Cárdenas G, Díaz JV, Meléndrez MF, Cruzat CC. Physicochemical properties of edible films from chitosan composites obtained by microwave heating. Polym Bull. 2008;61:737–748. doi: 10.1007/s00289-008-0994-7. [DOI] [Google Scholar]
- 30.Lima CAS, Oliva R, Cárdenas G, Silva EN, Miranda LCM. Influence of the thermal annealing on the electrical resistivity and thermal diffusivity of Pd:Ag nanocomposites. Mater Lett. 2001;51:357–362. doi: 10.1016/S0167-577X(01)00321-4. [DOI] [Google Scholar]
- 31.Mary G, Bajpai SK, Chand N. Copper (II) Ions and Copper Nanoparticles-Loaded Chemically Modified Cotton Cellulose Fibers with Fair Antibacterial Properties. J Appl Polym Sci. 2009;113:757–766. doi: 10.1002/app.29890. [DOI] [Google Scholar]
- 32.Perelshtein I, Applerot G, Perkas N, Wehrschuetz E, Hasmann A, Guebitz G, Gedanken A. CuO–cotton nanocomposite: Formation, morphology, and antibacterial activity. Surf Coat Tech. 2009;204:54–57. doi: 10.1016/j.surfcoat.2009.06.028. [DOI] [Google Scholar]
- 33.Chunju Gu, Sun B, Wenhua Wu, Wang F, Zhu M. Synthesis, Characterization of Copper-Loaded Carboxymethyl-Chitosan Nanoparticles with Effective Antibacterial Activity. Macromol Symp. 2007;254:160–166. [Google Scholar]
- 34.Kim YH, Lee DK, Cha HG, Kim CW, Kang YC, Kang YS. Preparation and Characterization of the Antibacterial Cu Nanoparticle Formed on the Surface of SiO2 Nanoparticles. J Phys Chem B. 2006;110:24923–24928. doi: 10.1021/jp0656779. [DOI] [PubMed] [Google Scholar]
- 35.Wu X, Ye L, Liu K, Wang W, Wei J, Chen F, Liu C. Antibacterial properties of mesoporous copper-doped silica xerogels. Biomed Mater. 2009;4:1–6. doi: 10.1088/1748-6041/4/4/045008. [DOI] [PubMed] [Google Scholar]
- 36.Zhang N, Gao Y, Zhang H, Feng X, Cai H, Liu Y. Preparation and characterization of core–shell structure of SiO2@Cu antibacterial agent. Colloid Surf B–Biointerfaces. 2010;81:537–543. doi: 10.1016/j.colsurfb.2010.07.054. [DOI] [PubMed] [Google Scholar]
- 37.Petranovskii V, Panina L, Bogomolova E, Belostotskaya G. Microbiologically active nanocomposite media. Proceedings of SPIE. 2003;5218:244–255. doi: 10.1117/12.506532. [DOI] [Google Scholar]
- 38.Stanić V, Dimitrijević S, Antić-Stanković J, Mitrić M, Jokić B, Plećaš IB, Raičević S. Synthesis, characterization and antimicrobial activity of copper and zinc doped hydroxyapatite nanopowders. Appl Surf Sci. 2010;256:6083–6089. doi: 10.1016/j.apsusc.2010.03.124. [DOI] [Google Scholar]
- 39.Hsiao MT, Chen SF, Shieh DB, Yeh CS. One-Pot Synthesis of Hollow Au3Cu1 Spherical-like and Biomineral Botallackite Cu2(OH)3Cl Flowerlike Architectures Exhibiting Antimicrobial Activity. J Phys Chem B. 2006;110:205–210. doi: 10.1021/jp054827x. [DOI] [PubMed] [Google Scholar]
- 40.Esteban-Tejeda L, Malpartida F, Esteban-Cubillo A, Pecharromán C, Moya JS. Antibacterial and antifungal activity of a soda-lime glass containing copper nanoparticles. Nanotechnology. 2009;20:505701–505707. doi: 10.1088/0957-4484/20/50/505701. [DOI] [PubMed] [Google Scholar]
- 41.Reetz MT, Helbig W. Size-selectivesynthesis of nanostructured transition-metal clusters. J Am Chem Soc. 1994;116:7401–7402. doi: 10.1021/ja00095a051. [DOI] [Google Scholar]
- 42.Cioffi N, Torsi L, Ditaranto N, Sabbatini L, Zambonin PG. Antifungal activity of polymer-based copper nanocomposite coatings. Appl Phys Lett. 2004;85:2417–2419. doi: 10.1063/1.1794381. [DOI] [Google Scholar]
- 43.Cioffi N, Torsi L, Ditaranto N, Picca RA, Tantillo G, Sabbatini L, Zambonin PG. Synthesis analytical characterization and bio‐activity of Ag‐ and Cu‐containing nano‐structured membranes. J Appl Biomat Biomec. 2004;2:200. [Google Scholar]
- 44.Cioffi N, Ditaranto N, Torsi L, Picca RA, De Giglio E, Sabbatini L, Novello L, Tantillo G. Synthesis, analytical characterization and bioactivity of Ag and Cu nanoparticles embedded in poly-vinyl-methyl-ketone films. Anal Bioanal Chem. 2005;382:1912–1918. doi: 10.1007/s00216-005-3334-x. [DOI] [PubMed] [Google Scholar]
- 45.Cioffi N, Torsi L, Ditaranto N, Tantillo G, Ghibelli L, Sabbatini L, Bleve-Zacheo T, D’Alessio M, Zambonin PG, Traversa E. Copper Nanoparticle/Polymer Composites with Antifungal and Bacteriostatic Properties. Chem Mater. 2005;17:5255–5262. doi: 10.1021/cm0505244. [DOI] [Google Scholar]
- 46.Ditaranto N, Loperfido S, van der Werf I, Mangone A, Cioffi N, Sabbatini L. Synthesis and analytical characterisation of copper-based nanocoatings for bioactive stone artworks treatment. Ana. Bioanal Chem. 2011;399:473–481. doi: 10.1007/s00216-010-4301-8. [DOI] [PubMed] [Google Scholar]
- 47.Cioffi N, Ditaranto N, Sabbatini L, Torsi L, Zambonin PG (2008) European Patent Application 9 pp Application: EP 2008-EP2123797A1
- 48.Cioffi N, Ditaranto N, Torsi L, Picca RA, Sabbatini L, Valentini A, Novello L, Tantillo G, Bleve-Zacheo T, Zambonin PG. Analytical characterization of bioactive fluoropolymer ultra-thin coatings modified by copper nanoparticles. Anal Bioanal Chem. 2005;381:607–616. doi: 10.1007/s00216-004-2761-4. [DOI] [PubMed] [Google Scholar]
- 49.Kelly PJ, Li H, Benson PS, Whitehead KA, Verran J, Arnell RD, Iordanova I. Comparison of the tribological and antimicrobial properties of CrN/Ag, ZrN/Ag, TiN/Ag, and TiN/Cu nanocomposite coatings. Surf Coat Tech. 2010;205:1606–1610. doi: 10.1016/j.surfcoat.2010.07.029. [DOI] [Google Scholar]
- 50.Ivanov-Omskii VI, Panina LK, Yastrebov SG. Amorphous hydrogenated carbon doped with copper as antifungal protective coating. Carbon. 2000;38:495–499. doi: 10.1016/S0008-6223(99)00121-9. [DOI] [Google Scholar]
- 51.Kelly PJ, Li H, Whitehead KA, Verran J, Arnell RD, Iordanova I. A study of the antimicrobial and tribological properties of tin/Ag nanocomposite coatings. Surf Coat Tech. 2009;204:1137–1140. doi: 10.1016/j.surfcoat.2009.05.012. [DOI] [Google Scholar]
- 52.Chang YJ, Li CL, Lee JW, Wu FB, Chang LC. Evaluation of antimicrobial abilities of Cr2N/Cu multilayered thin films. Thin Solid Films. 2010;518:7551–7556. doi: 10.1016/j.tsf.2010.05.046. [DOI] [Google Scholar]
- 53.Zhang W, Zhang YH, Ji JH, Zhao J, Yan Q, Chu PK. Antimicrobial properties of copper plasma-modified polyethylene. Polymer. 2006;47:7441–7445. doi: 10.1016/j.polymer.2006.08.057. [DOI] [Google Scholar]
- 54.Chu PK. Recent developments and applications of plasma immersion ion implantation. J Vac Sci Technol B. 2004;22:289–296. doi: 10.1116/1.1632920. [DOI] [Google Scholar]
- 55.Chu PK, Tang BY, Wang LP, Wang XF, Wang SY, Huang N. Third-generation plasma immersion ion implanter for biomedical materials and research. Rev Sci Instrum. 2001;72:1660–1665. doi: 10.1063/1.1340029. [DOI] [Google Scholar]
- 56.Zhang W, Zhang Y, Ji J, Yan Q, Huang A, Chu PK. Antimicrobial polyethylene with controlled copper release. J Biomed Mater A. 2007;83:838–844. doi: 10.1002/jbm.a.31436. [DOI] [PubMed] [Google Scholar]
- 57.Ren G, Hu D, Cheng EWC, Vargas-Reus MA, Reip P, Allaker RP. Characterisation of copper oxide nanoparticles for antimicrobial applications. Int J Antimicrob Ag. 2009;33:587–590. doi: 10.1016/j.ijantimicag.2008.12.004. [DOI] [PubMed] [Google Scholar]
- 58.Yates HM, Brook LA, Sheel DW, Ditta IB, Steele A, Foster HA. The growth of copper oxides on glass by flame assisted chemical vapour deposition. Thin Solid Films. 2008;517:517–521. doi: 10.1016/j.tsf.2008.06.071. [DOI] [Google Scholar]
- 59.Medina C, Santos-Martinez MJ, Radomski A, Corrigan OI, Radomski MW. Nanoparticles: Pharmacological and toxicological significance. Brit J Pharmacol. 2007;150:552–558. doi: 10.1038/sj.bjp.0707130. [DOI] [PMC free article] [PubMed] [Google Scholar]
- 60.Radetić M, Illić V, Vodnik V, Dimitrijević S, Jovančić P, Šaponjić Z, Nedeljković JM. Antibacterial effect of silver nanoparticles deposited on corona-treated polyester and polyamide fabrics. Polym Adv Technol. 2008;19:1816–1821. doi: 10.1002/pat.1205. [DOI] [Google Scholar]
- 61.Anon BS N 697:2001 Chemical Disinfectants and Antiseptics - Quantitative Non-porous Surface Test for the Evaluation of Bactericidal and/or Fungicidal Activity of Chemical Disinfectants Used in Food, Industrial, Domestic and Institutional Areas - Test Method and Requirements Without Mechanical Action (phase 2/step 2), British Standards Institution, London (2001)




